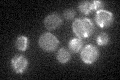
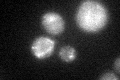
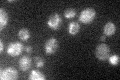

View description
Farnesyl pyrophosphate synthetase, has both dimethylallyltranstransferase and geranyltranstransferase activities; catalyzes the formation of C15 farnesyl pyrophosphate units for isoprenoid and sterol biosynthesis
Localization:
Intensity:
Fold change:
Significance:
-
C’ GFP library in SD
mitochondria21.66 -
N' NOP1pr-GFP in SD

N/A0 -
N' TEF2pr-mCherry in SD

N/A0 -
N' NATIVEpr-GFP in SD

N/A0 -
N' TEF2pr-VC and Cyto-VN in SD

N/A0 -
C’ GFP library in SD+DTT
mitochondria19.950.92No -
C’ GFP library in SD+H2O2

mitochondria22.61.04No -
C’ GFP library in Starvation Media
mitochondria31.381.44Yes -
C’ GFP library on the background of Pup2-DaMP

mitochondria -
C’ GFP library on the background of CCT mutant

mitochondria18.17510.83876No
